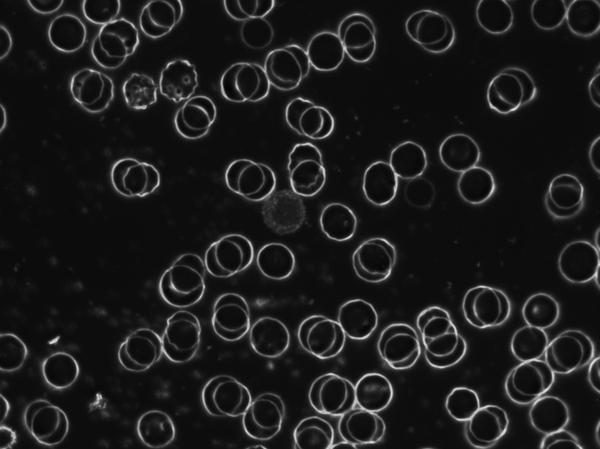

Live Blood Analysis & Food Sensitivity Testing Offer!
Published: Fri, 01/23/15
Save 50% when Purchasing a Live Blood Analysis with or without a Food Sensitivity
Test with John Way ***ONLY 20 CONSULTATIONS ON OFFER SO BOOK NOW TO AVOID DISAPPOINTMENT!*** Offer only on consultations booked after 1st Feb 2015 Click here to book online Use code blood15 to redeem your discount |